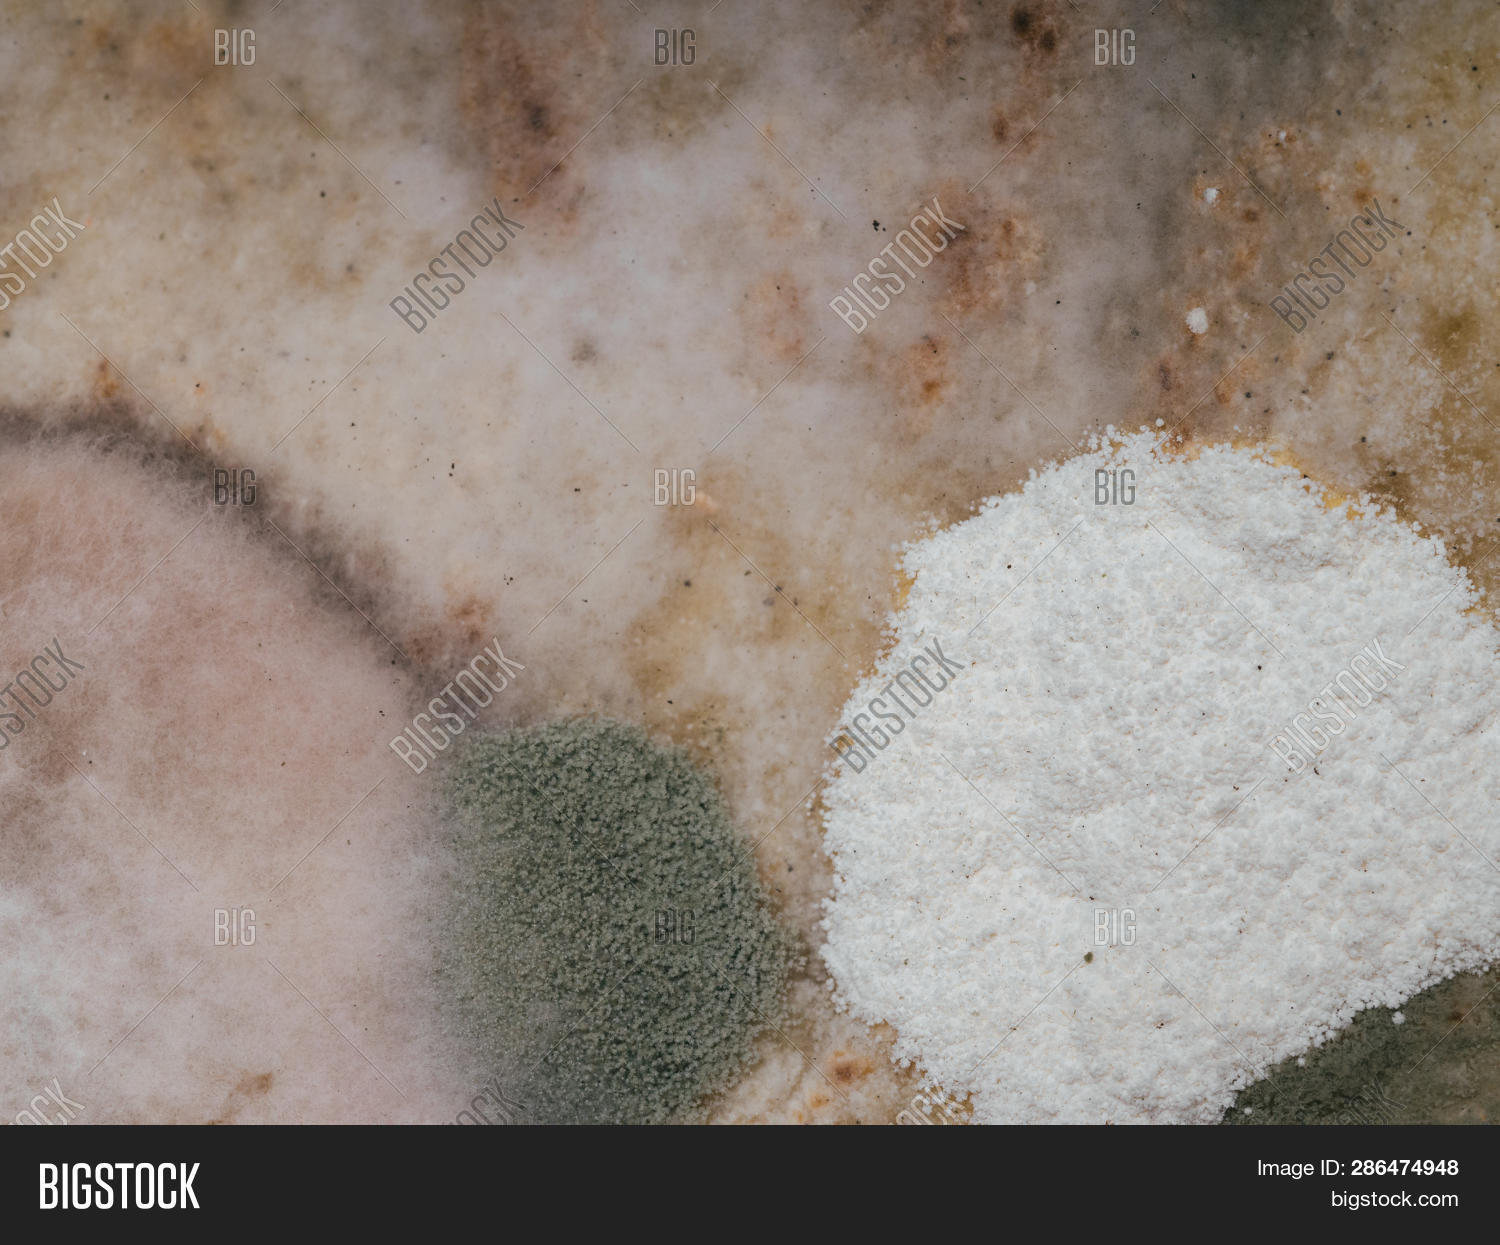
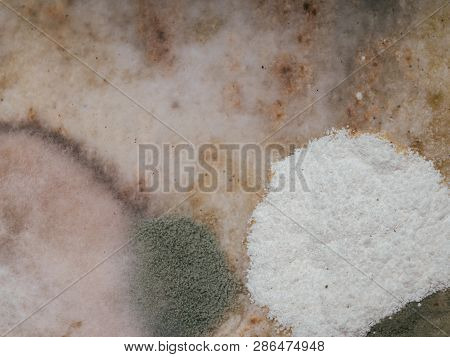
Spoiled Moldy Old Bread With Spores Of The Fungus Macro

sulje
Kuva
kuvat
spoiled moldy old bread with spores of the fungus macro
| Arkistokuvan tunnus: 286474948 |
| Tekijänoikeus: alexkoral |
Käytettävissä laajennetulle käyttöluvalle.
Lataa minkä kokoinen kuva tahansa samaan hintaan
| 5 kuvaa päivässä | $0.53 / Kuva | $79 |
| 10 kuvaa päivässä | $0.33 / Kuva | $99 |
| 50 kuvaa kuukaudessa | $1.58 / Kuva | $79 |
Krediitit kelpaavat enintään vuoden
| 10 Kolikkoa | $35 | |
| 25 Kolikkoa | säästät 44 % | $49 |
| 100 Kolikkoa | säästät 52 % | $169 |
| 500 Kolikkoa | säästät 72 % | $495 |
Tallenna tämän kuvan esikatselu google driveen.